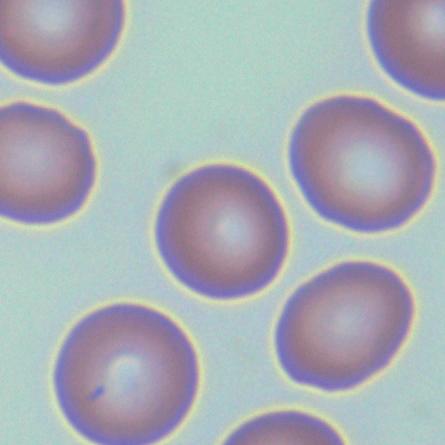
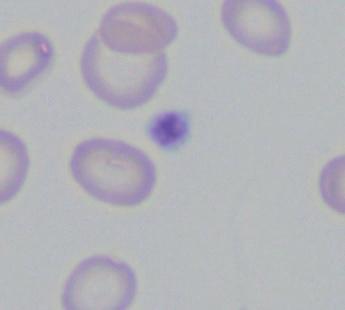

Hematologie


voor de basisarts

D/2021/45/424 – ISBN 978 94 014 8052 9 – NUR 870, 871
Vormgeving omslag: Studio Lannoo Vormgeving binnenwerk: Crius Group Afbeeldingen en illustraties: Somersault 18:24
© Peter Vandenberghe & Uitgeverij Lannoo nv, Tielt, 2023.
Uitgeverij LannooCampus maakt deel uit van Lannoo Uitgeverij, de boeken- en multimediadivisie van Uitgeverij Lannoo nv.
Alle rechten voorbehouden.
Niets van deze uitgave mag verveelvoudigd worden en/of openbaar gemaakt, door middel van druk, fotokopie, microfilm, of op welke andere wijze dan ook, zonder voorafgaande schriftelijke toestemming van de uitgever.
Uitgeverij LannooCampus
Vaartkom 41 bus 01.02 Postbus 23202
3000 Leuven 1100 DS Amsterdam België Nederland
www.lannoocampus.com
Afkortingen
Afkorting Voluit
2,3-BPG 2,3-bisfosfoglyceraat
AA aplastische anemie
ABC activated B-cell
ACD, AOCD anemia of chronic disease (anemie van chronische ziekte)
ADAMTS13 a disintegrin and metalloproteinase with a thrombospondin type 1 motif, member 13
aHUS atypisch hemolytisch uremisch syndroom
AIDS acquired immunodeficiency syndrome
AIHA auto-immune hemolytische anemie
ALL acute lymfoblastische leukemie
AML acute myeloïde leukemie
AP acceleratiefase (acceleration phase)
APL acute promyelocytenleukemie
aPTT geactiveerde partiële tromboplastinetijd
ATP adenosinetrifosfaat
B-CLL chronische lymfatische leukemie van B-celorigine
BCMA B-cell maturation antigen
BCR B-celreceptor voor antigeen
BL Burkittlymfoom
BP blastenfase (blast phase)
BTK Bruton tyrosine kinase
CAD cold agglutinin disease
CALR calreticuline
CAR chimere antigeenreceptor
CD cluster of differentiation
cDNA copy DNA
CEL chronische eosinofiele leukemie
cfDNA cell-free DNA (celvrij DNA)
CFU-GM granulocyte/monocyte colony-forming unit
CHIP clonal hematopoiesis of indeterminate potential
CLP common lymphoid precursor (gemeenschappelijke lymfoïde voorloper)
CML chronische myeloïde leukemie
CMML chronische myelomonocytaire leukemie
CMP common myeloid precursor (gemeenschappelijke myeloïde voorloper)
CMV cytomegalovirus
CNB core needle biopsy
CNL chronische neutrofilaire leukemie
CO koolstofmonoxide
cofo complet-formule
CP chronic phase (chronische fase)
CRAB calcium, renal, anemia, bone (calcium, renaal, anemie, bot)
CRP C-reactive protein
CSF3R receptor voor G-CSF (granulocyte colony stimulating factor)
CT computed tomography
ctDNA circulating tumor DNA (circulerend tumor-DNA)
DAF decay-accelerating factor
DARC Duffy antigen receptor for chemokines
DAT directe antiglobulinetest
DCML dendritic cell, monocyte, B and NK lymphoid deficiency
DEB di-epoxybutaan
DHPLC denaturing high performance liquid chromatography
DIC diffuse intravascular coagulation (diffuse intravasale stolling)
DLBCL diffuse large B-cell lymphoma (diffuus grootcellig B-cellymfoom)
EBNA Epstein-Barr virus nuclear antigen
EBV Epstein-Barrvirus
ECL erytrocytenconcentraat
EGPA eosinofiele granulomatose met polyangiïtis
EPO erytropoëtine
EPO-R receptor voor erytropoëtine
ERFE erytroferrone
ET essentiële trombocytemie
FFP fresh frozen plasma
FFPE formalin-fixed paraffin-embedded
FISH fluorescence in situ hybridisation (fluorescente in-situ hybridisatie)
FLAER fluoresceïnegemerkt aerolysine
FLC free light chains (vrije lichte ketens)
FLIPI follicular lymphoma international prognostic index
FNAC fine needle aspiration cytology (fijne-naaldaspiratiecytologie)
G6PD glucose-6-fosfaatdehydrogenase
GCB germinal center B-cell
G-CSF granulocyte-colony-stimulating factor
GM-CSF granulocyte/monocyte colony-stimulating factor
GVHD graft versus host disease
HbA hemoglobine A
HbA2 hemoglobine A2
HbC hemoglobine C
HbF hemoglobine F (foetaal hemoglobine)
HbS hemoglobine S
HBV hepatitis B-virus
Hct hematocriet
HCL hairy cell leukemia
HCV hepatitis C-virus
HE hematoxyline/eosine
HE hypereosinofilie
HELLP hemolysis, elevated liver tests, low platelets
HEUS hypereosinophilia of undetermined significance (hypereosinofilie van ongekende betekenis)
HFrEF heart failure with reduced ejection fraction
HIF hypoxia-inducible factor
HIV human immunodeficiency virus
HL Hodgkinlymfoom
HLA human leukocyte antigen
HPLC high-pressure liquid chromatography
HSC hematopoietic stem cell (hematopoëtische stamcel)
HTLV-I human T-lymphotropic virus type 1
HTLV-II human T-lymphotropic virus type 2
HUS hemolytic uremic syndrome (hemolytisch uremisch syndroom)
HVGD host versus graft disease
IFN-α interferon-α
iFOB immunological fecal occult blood test (immunologische test voor occult fecaal bloed)
IGH Locus van de zware keten van immunoglobuline
IGK Locus van de lichte keten kappa van immunoglobuline
IGL Locus van de lichte keten lambda van immunoglobuline
IgVH DNA-sequentie van het variabel domein van de zware keten
iHES idiopathic hypereosinophilic syndrome (idiopathisch hypereosinofiel syndroom)
IL interleukine
IPI international prognostic index (IPI) voor diffuus grootcellig B-cellymfoom
ITP immune trombocytopenie
IVIG intraveneuze immunoglobulines
JMML juveniele myelomonocytaire leukemie
kAIHA koude auto-immune hemolytische anemie
LLOD lower limit of detection
LOD limit of detection
MAC membrane attack complex
MALT mucosa associated lymphoid tissue
MBL monoclonal B-cell lymphocytosis (monoklonale B-cellymfocytose)
MCH mean corpuscular hemoglobin
MCHC mean corpuscular hemoglobin concentration
MCL mantle cell lymphoma (mantelcellymfoom)
MCV mean corpuscular volume
MDS myelodysplastische neoplasmen
MEP megakaryocyte/erythrocyte precursor
MGCS monoclonal gammopathy of clinical significance
MGNS monoclonal gammopathy of neurological significance
MGRS monoclonal gammopathy of renal significance
MGUS monoclonal gammopathy of undetermined significance
MHC major histocompatibility complex (majeur histocompatibiliteitscomplex)
MIPI mantle cell lymphoma international prognostic index
MIRL membrane inhibitor of reactive lysis
monoMAC monocytopenie en mycobacterium aviumcomplex
MPL thrombopoietin receptor (membraanreceptor voor trombopoëtine)
MPN myeloproliferative neoplasm(s) (myeloproliferatieve neoplasme(n))
MR magnetische resonantie
MRD minimal residual disease (minimale residuele ziekte) measurable residual disease (meetbare residuele ziekte)
MZL marginal zone lymphoma (marginale-zonelymfoom)
NADPH nicotinamide adenine dinucleotide phosphate
NGS next generation sequencing
NHL non-hodgkinlymfoom
NO nitric oxide
NSAID non-steroidal anti-inflammatory drug
OGM optical genome mapping
PCR polymerase chain reaction
PCV packed cell volume
PET positron emission tomography (positronenemissietomografie)
PMF primaire myelofibrose
PNH paroxismale nocturne of nachtelijke hemoglobinurie
PRCA pure red cell aplasia
PT protrombinetijd
PV polycythemia vera
RDW red cell distribution width
Rh rhesus
rh recombinant humaan
RNA-Seq RNA-sequencing
RS Richtersydroom
RT-PCR reverse-transcriptase PCR
SAA severe aplastic anemia (ernstige aplastische anemie)
SCF stem cell factor
SCN severe chronic neutropenia (ernstige chronische neutropenie)
SLE systemic lupus erythematosus, systemische lupus erythematodes
SLL small lymphocytic lymphoma (kleincellig B-lymfocytair lymfoom)
SOA seksueel overdraagbare aandoening
TACO transfusion associated cardiac overload
TA-GVHD transfusion associated graft versus host disease
TCB Tru cut biopsy, through cut biopsy
TCR T-cell receptor for antigen (T-celreceptor voor antigeen)
TKI tyrosine kinase inhibitor (inhibitor van tyrosinekinase)
T-LGL T-large granular lymphocyte
TMA thrombotic microangiopathy (trombotische microangiopathie)
TNF-α tumor necrosis factor α
TPO trombopoëtine
TRALI transfusion associated lung injury
VCA viral capsid antigen
VDJ variable diversity joining region
Vit B12 vitamine B12
VPVIM vers ingevroren virusgeïnactiveerd menselijk plasma
vWF von Willebrandfactor
wAIHA warme auto-immune hemolytische anemie
WES whole exome sequencing
WGS whole genome sequencing
Wysiwig what you see is what you get what you search is what you get
Hoofdstuk 1
Het hematopoëtische stelsel en zijn onderzoek
1.1 BLOED EN HEMATOPOËSE

1.1.1 Bloed
1.1.1.1 Rode bloedcellen of erytrocyten
In het perifere bloed zijn rode bloedcellen verantwoordelijk voor het zuurstoftransport van de longen naar de perifere weefsels, en omgekeerd voor het transport van CO2 van de perifere weefsels naar de longen.
Tabel 1.1 geeft weer welke erytroïde cellen in het bloed aanwezig (kunnen) zijn. Mature rode bloedcellen (erytrocyten) hebben een typische, biconcave vorm, met een maximale diameter van 6-8 µm, als een donut. Ze hebben geen kern of DNA, er is ook geen RNA meer in het cytoplasma. Ze zijn in grote aantallen aanwezig in het bloed.
Reticulocyten zijn jongere rode bloedcellen en zijn iets groter (8-12 µm). Ze hebben net als rijpe erytrocyten geen kern maar bevatten wel nog RNA in het cytoplasma. Dat RNA kan met specifieke kleuringen worden gevisualiseerd als een netwerkachtig ‘reticulair’ patroon: vandaar de naam reticulocyten. Reticulocyten vertegenwoordigen een kleine fractie van de rode bloedcellen in normaal perifeer bloed.
De normoblast gaat de reticulocyt vooraf in de rijping tot erytrocyt. Een normoblast is 10-15 µm groot, groter dus dan een reticulocyt, heeft wel een kern en een sterk basofiel cytoplasma. Die cel bevat dus wel nog DNA en uiteraard ook RNA. Pas wanneer de normoblast zijn kern heeft uitgestoten, zal de jonge reticulocyt het beenmerg verlaten en in het perifeer bloed verschijnen. De normoblast komt normalerwijze enkel voor in het beenmerg, en de aanwezigheid ervan in perifeer bloed wijst steeds op een pathologische situatie.
De erytrocyt zit volgepakt met hemoglobine. Hemoglobine is een tetrameer van twee plus twee identieke eiwitten, globines, elk met een eigen heemkern. Bij de volwassene is de dominante vorm hemoglobine A (HbA), dat bestaat uit twee alfaketens en twee bètaketens (α2β2).
1.1.1.2 Witte bloedcellen of leukocyten
In perifeer bloed zijn er drie types witte bloedcellen: granulocyten, lymfocyten en monocyten (tabel 1.2).





Granulocyten
Granulocyten zijn vrij grote cellen met een korrelig granulair cytoplasma, vandaar hun naam. De korrels in het cytoplasma kunnen neutrofiel, eosinofiel of basofiel aankleuren, vandaar de onderverdeling in neutrofiele, eosinofiele en basofiele granulocyten.
De neutrofiele granulocyt is kwantitatief veruit het sterkst vertegenwoordigd in het perifere bloed. De neutrofiel heeft een zeer korte verblijfsduur in het perifere bloed: het stabiele neutrofielenaantal impliceert dus dat voortdurend hoge aantallen neutrofielen door de granulopoëse in het beenmerg worden aangemaakt. Eosinofiele granulocyten en basofiele granulocyten vertegenwoordigen een veel kleinere fractie van het totale aantal witte bloedcellen in het perifere bloed. Hun verblijfsduur in het perifere bloed is in de ordegrootte van dagen.
Deze drie celtypes spelen een belangrijke rol In de eerstelijnsimmuniteit tegen bacteriën, fungi en parasieten: de zogenoemde aangeboren immuniteit of innate immunity.
Lymfocyten en de perifere lymfeklieren
Lymfocyten zijn 7-10 µm groot, groter dus dan een rode bloedcel maar kleiner dan monocyten en granulocyten. Na de granulocyten vertegenwoordigen ze de grootste fractie van de witte bloedcellen. Lymfocyten hebben een dense ronde kern en een dun randje cytoplasma. Met behulp van monoklonale antistoffen kunnen we lymfocyten onderverdelen in B-lymfocyten, T-lymfocyten en natural killer (NK)-cellen, maar louter morfologisch kunnen die cellen niet van elkaar onderscheiden worden. Lymfocyten zijn verantwoordelijk voor de verworven antigeenspecifieke immuniteit: B-lymfocyten voor de productie van antistoffen, T-cellen voor cellulaire immuniteit tegen virussen en tumorcellen. De opbouw van immunologische antwoorden van T- of B-lymfocyten vindt plaats in de perifere lymfoïde organen, namelijk lymfeklieren en milt.
Monocyten en het reticulo-endotheliale systeem Het laatste celtype in het perifere bloed is de monocyt. De monocyt is even groot tot iets groter dan de granulocyt en verblijft opnieuw relatief kortdurend in het perifere bloed. Monocyten maken net zoals eosinofielen en basofielen een kleine fractie uit. Zij spelen een rol in de eerstelijnsimmuniteit tegen bacteriën en fungi. Monocyten verlaten vrij snel het perifere bloed naar de perifere weefsels, waar ze lange tijd kunnen overleven. In de weefsels vervullen ze de rol van professionele fagocyten (macrofagen). Ook kunnen ze ontwikkelen tot cellen met gespecialiseerde functies, zoals de mesangiale cellen in de nier,
microglia in de hersenen, alveolaire macrofagen in de long, en Küpffercellen in de lever. Ook kunnen ze dendritische cellen worden met een belangrijke functie als antigeenpresenterende cel in het immuunsysteem.
1.1.1.3 Bloedplaatjes of trombocyten
Ten slotte zijn er bloedplaatjes of trombocyten (tabel 1.3). Die zijn verantwoordelijk voor de eerste fase van de bloedstelping. Bloedplaatjes zijn slechts enkele micrometer groot en dus de kleinste elementen in het perifere bloed. Hun cytoplasma is basofiel en granulair. Ze hebben geen kern. Ze zijn in zeer grote aantallen aanwezig, en hun levensduur in het bloed bedraagt ongeveer tien dagen.
1.1.2 Het beenmerg
De cellen die circuleren in het perifere bloed worden gevormd in de bloedvormende organen. Bij gezonde personen ouder dan vier tot vijf maanden is het beenmerg de exclusieve plaats van de hematopoëse.
In het foetale leven begint de vroegste primitieve hematopoëse in de dooierzak, om zich na enkele weken te verplaatsen naar de lever en de milt. Aan het einde van het intra-uteriene leven wijkt de hematopoëse uit naar het beenmerg. Vanaf de postnatale leeftijd van vier tot vijf maanden vindt de hematopoëse bij gezonde personen exclusief plaats in het beenmerg. Bij de zuigeling neemt de hematopoëse nog het volledige skelet in: het beenmerg is dan in elk bot rood. Bij volwassenen trekt de hematopoëse zich terug tot het axiale skelet en de proximale tubulaire beenderen: de schedel, wervelzuil, sternum, ribben en bekken, en de proximale delen van femora en humeri. Dat bepaalt ook welke plaatsen bij jonge kinderen versus volwassenen in aanmerking komen voor een beenmergpunctie.
Figuur 1.1 Hematopoëse: vorming van bloedcellen in het beenmerg.

HSC: hematopoëtische stamcel; CLP: common lymphoid progenitor/gemeenschappelijke lymfoïde voorloper; CMP: common myeloid precursor/gemeenschappelijke myeloïde voorloper; GMP: granulocyte/monocyte precursor/voorloper van granulocyten en monocyten; MEP: megakaryocyte/erythroocyte precursor/voorloper van megakaryocyten en ery trocyten; MkP: megakaryocytaire precursor/voorloper; ErP: erytrocytaire precursor/voorloper; NK-cellen: natural killer cellen.





















































































































Bij pathologische condities, waarbij het beenmerg er niet in slaagt om voldoende bloed te vormen, kan opnieuw extramedullaire hematopoëse ontstaan in lever of milt, wat dan leidt tot hepato- en/of splenomegalie.
De hematopoëse is een zeer actief proces met een buitengewone regeneratiecapaciteit. Schematisch kan dat proces worden ingedeeld in drie fasen of drie compartimenten: 1) het compartiment van de pluripotente hematopoëtische stamcel; 2) het compartiment waar de multipotente progenitor uitrijpt tot herkenbare hematopoëtische voorlopers, en 3) het compartiment waarin mature bloedelementen zich hebben gevormd.


De pluripotente hematopoëtische stamcel is een zeldzame cel die zich in speciale hematopoëtische niches bevindt. In die niches in het beenmerg is ze beschermd en afgeschermd van mogelijke toxische of schadelijke invloeden. De hematopoëtische stamcel is pluripotent: ze kan naar verschillende weefseltypes differentiëren. Een karakteristieke membraanmerker voor die cel is CD34. Overigens draagt die cel geen antigenen die aanwezig zijn op de specifieke celtypes die zich als afstammelingen van de hematopoëtische stamcel kunnen ontwikkelen (lineage negative).
Collectief vormen de hematopoëtische stamcellen de zogenoemde stamcelpool. Dat is een mitotisch weinig actieve, ‘slapende’ populatie van cellen. Als die cellen delen, dan genereren ze zowel multipotente progenitorcellen als nieuwe hematopoëtische stamcellen. Dat noemt men ‘asymmetrische deling’. Multipotente progenitorcellen zijn voorbestemd om te differentiëren tot mature cellen. Vorming van nieuwe hematopoëtische stamcellen vermijdt dat de deling van hematopoëtische stamcellen naar multipotente progenitorcellen leidt tot leegloop van het stamcelcompartiment. Door de asymmetrische deling is het stamcelcompartiment dus in staat tot self renewal, om de hematopoëse levenslang te kunnen onderhouden.
Multipotente progenitorcellen zijn voorbestemd om te differentiëren naar mature bloedcelelementen. Initieel ligt het accent op snelle proliferatieve activiteit, maar geleidelijk aan zullen hun afstammelingen hun intense delingscapaciteit verliezen en steeds meer differentiëren. Dat differentiatiepad wordt gecontroleerd en gestuurd door een complex samenspel van transcriptiefactoren. Een beslissing die multipotente progenitorcellen relatief vroeg in het differentiatiepad moeten nemen, is de keuze tussen een verder bestaan als lymfocyt of als myeloïde cel (Figuur 1.1).
Vanaf de gemeenschappelijke lymfoïde voorloper (common lymphoid precursor, CLP) verloopt de ontwikkeling van lymfoïde progenitoren verder over pro-B-, pro-T- en pro-NK-cellen om finaal mature antigen-naïeve B- en T-lymfocyten en NK-cellen te worden.
Vanaf de gemeenschappelijke myeloïde voorloper (common myeloid precursor, CMP) ontwikkelen cellen zich tot megakaryocytaire/erytroïde voorlopers of tot granulocytaire/monocytaire voorlopers. Megakaryocytaire/erytroïde voorlopers genereren erytroïde en megakaryocytaire voorlopers. Uit de granulocytaire/monocytaire voorlopers ontspringen granulocytaire en monocytaire progenitoren.
Met uitzondering van monocyten en macrofagen zijn de mature elementen van de myelopoëse allemaal postmitotisch: ze zijn terminaal gedifferentieerd, met verlies van hun mitotische delingscapaciteit. Voor het lymfoïde compartiment is dat niet het geval, want primaire antigen-naïeve T- en B-cellen moeten later in staat zijn om een proliferatieve immuunrespons te ontwikkelen na herkenning van een antigen in de secundaire lymfoïde organen. Het verlies van mitosecapaciteit in mature cellen van myeloïde origine verklaart waarom maligniteiten van de myelopoëse enkel in het beenmerg ontstaan. Maligniteiten van de lymfopoëse kunnen daarentegen zowel in het beenmerg als in de perifere lymfoïde organen hun oorsprong vinden.
1.2 DIAGNOSTIEK VAN HEMATOLOGISCHE AANDOENINGEN
De diagnose van hematologische aandoeningen vertrekt uiteraard bij klachten en klinisch onderzoek van een patiënt. De diagnostiek berust op twee grote pijlers: enerzijds weefselonderzoek en anderzijds beeldvorming.
1.2.1 Anamnese en klinisch onderzoek bij hematologische aandoeningen
Elke diagnose begint bij het klachtenpatroon (anamnese) en het klinische onderzoek van de zieke (Figuur 1.2).
De belangrijkste functie van rode bloedcellen bestaat uit zuurstoftransport van longen naar de weefsels, en stoornissen in de rode bloedcellen zullen zich dus vaak uiten als tekort aan oxygenatie in de perifere weefsels: vermoeidheid, gedaalde inspanningscapaciteit, abnormale dyspneu, cardiale klachten van ischemie, tachycardie, ritmestoornissen of decompensatie, of optreden van neuropsychologische stoornissen. Rode bloedcellen en hun afbraakmetabolieten zijn ook verantwoordelijk voor de kleur van de huid. Bij een vermoeden van hematologische pathologie moet daarom altijd de huidskleur beoordeeld worden.
Witte bloedcellen zijn verantwoordelijk voor de verdediging tegen infecties. Patiënten met bloedziekten melden zich vaak met verhoogde kwetsbaarheid voor infecties. Witte bloedcellen vinden hun normale biotoop in beenmerg
